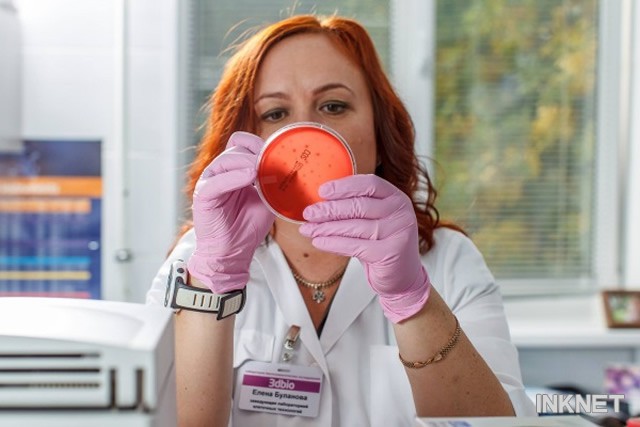

日前,俄羅斯一著名3D打印公司3D Bioprinting Solutions宣布將于十月中旬發(fā)布一款3D生物打印機。截至目前,3D打印機的詳細信息尚不知曉。

研究生物墨水 圖源:3ders
透露的3D生物打印機信息:
噴嘴數(shù)量:五個
功用:器官再造,其他功能不詳
打印材料:自行研制的生物墨水和生物紙(具體不詳)
技術(shù)支持:基于生物打印技術(shù)上的發(fā)展
軟件支持:笛卡爾坐標系統(tǒng)
成型技術(shù):逐層堆積,具體不詳
產(chǎn)品特點:兼容所有版本的生物打印技術(shù)、高分辨率

研究員 圖源:3ders
研究員 圖源:3ders
對于這款只透露部分規(guī)格的3D生物打印機,我們尚未具體了解,具體的技術(shù)規(guī)格還需等官方的發(fā)布。就目前所得到的信息而言,該公司已經(jīng)對這款3D打印機提出專利申請。3D打印機采用公司自己開發(fā)的軟件,可提前展現(xiàn)生物組織的效果圖。

圖源:3ders
即將發(fā)布的3D生物打印機在技術(shù)采用、功能以及打印質(zhì)量上都會有一定程度上的改進之處。目前,研究小組已經(jīng)建立超現(xiàn)代生物技術(shù)研究實驗室,研究3D打印材料生物墨水。

圖源:3ders
期待這款3D生物打印機在莫斯科召開的開放創(chuàng)新2014論壇上的亮相。



滬公網(wǎng)安備 31011702001106號